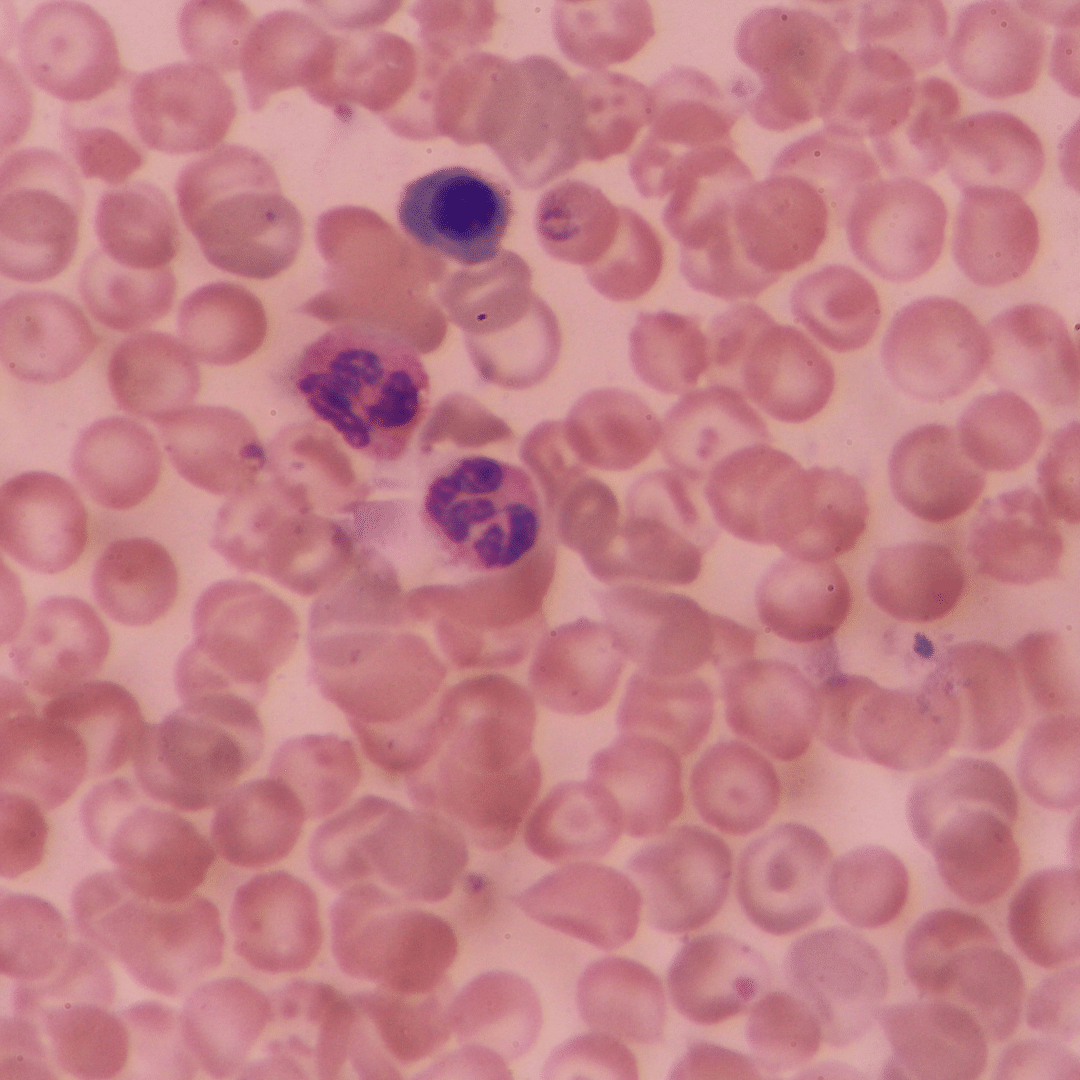
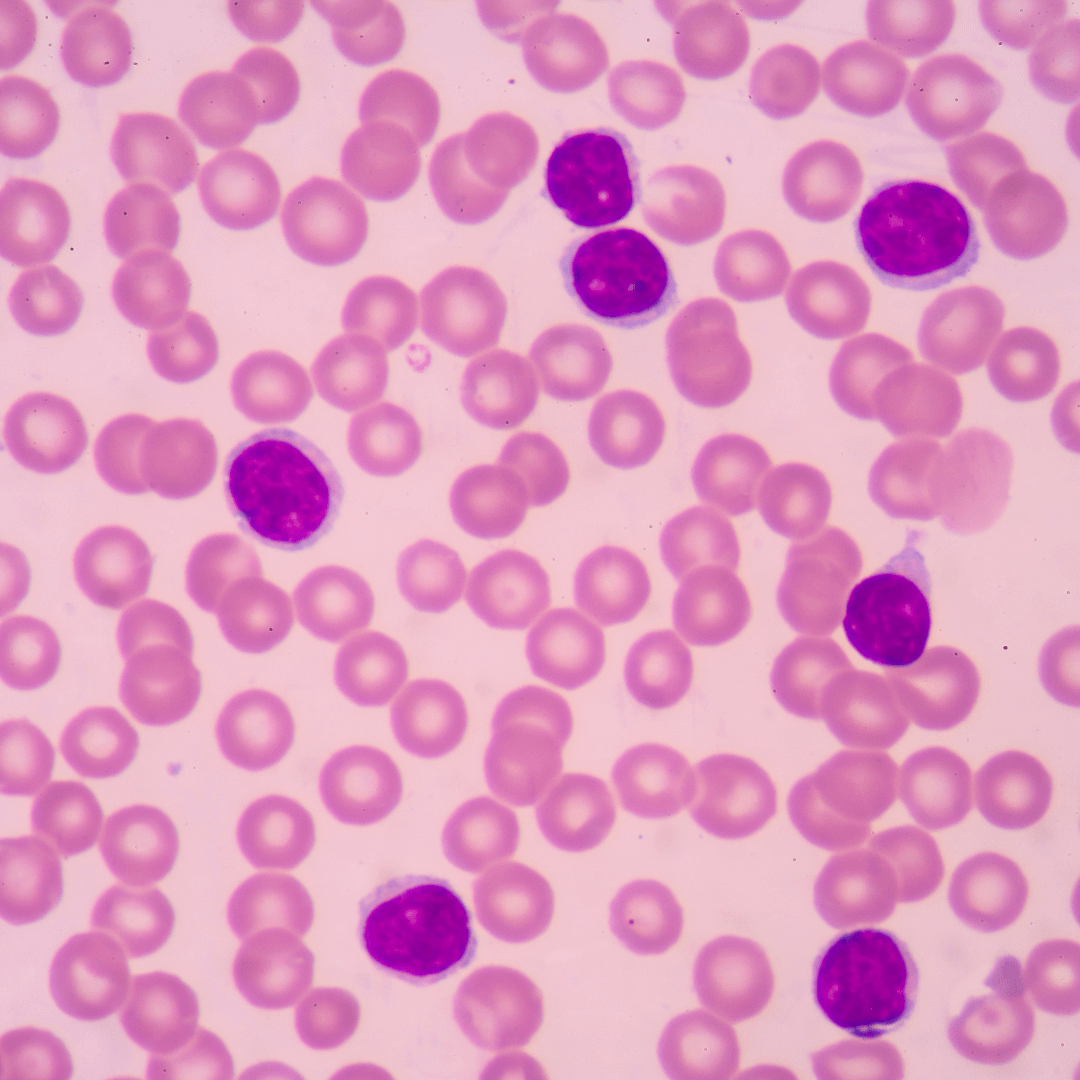

Testimonials
Explore Our Solutions...
FAQs
Our ingredients are from all over the world. When sourcing for the best quality ingredients, we look for speciations with the right potency and cleanliness (i.e. heavy metal test and biological test). There is the general misconception that ‘local' or North American ingredients are better quality. Instead of asking “where are the ingredients from”, we focus on the verification of the ingredients to ensure they are exactly what they are supposed to be.
Our products are manufactured in Canada and the US depending on the type of product; whether it is a powder, capsule, hard tablet, or soft gel. Some of our products are very specialized in their manufacturing process. Each of our facilities is GMP (Good Manufacturing Process) certified to ensure that high standards of quality control process are in place.
Eating well can be very subjective and also be influenced by so many factors. You need to consider not only the quantity of food but what the food you are eating contains. It also requires having a balanced approach to food including the different food groups, a good variety of foods to supply different nutrients, and to limit foods that have less nutritional value. Supplements should not be a substitute or crutch to compensate for a poor diet but should be used to fill the gaps that a diet may not provide or the extra demands of a busy or stressful lifestyle, family life, or work environment. Learn more here.
If you would like to share daily wellness with our community, you can apply to become a Community Member!
Share your passion for daily wellness while including Enerex Supplements and Luma Skincare products in your daily routine.
Our website contains a lot of great information about our products. We also have a library of On-Demand Webinars
If you still have more questions, you can reach us toll-free by phone +1(604)474-2000, email hello@enerex.ca, message us on What's App +1(604)474-0333, or send us a direct message on social media!
Once you’ve learned about our products, we always suggest to check with your health care professional for your specific needs.